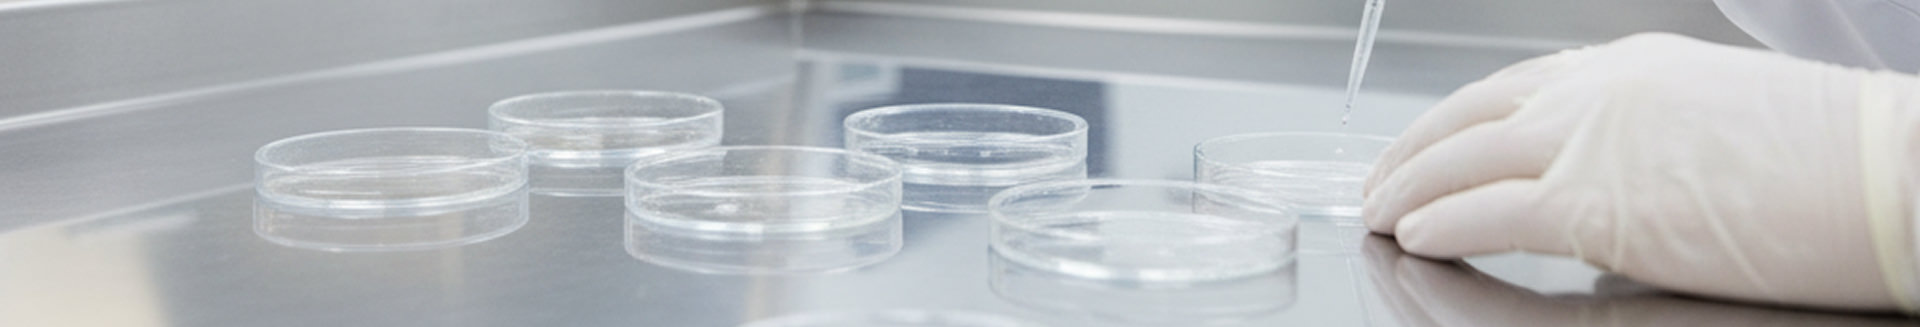
r&d background

Innovation Starts in the Lab
At the Chemtronics R&D Lab, ideas take shape as working solutions—this is where we push technology forward. Our team develops and tests new contact cleaning, flux removal, and electronics repair technologies that perform in the environments our customers work in every day.
We bring together formulation science and real-world process testing to develop solutions that are safer, more effective, and ready for production environments.
Inside the Chemtronics Lab
Process Evaluation
The first goal is to fully understand your production environment. What are you building? What contaminants or coatings are involved? What equipment do you rely on? This assessment helps us zero in on where the process is breaking down and where chemistry can make a difference.
Hands-On Testing with Real Components
We use your actual parts, materials, and residues to replicate your conditions as closely as possible. Our technicians conduct controlled cleaning and coating trials to capture data that reveals how each chemistry performs under realistic production stresses.
Tailored Formulation
Sometimes the solution already exists within our product line; but often, the best outcome comes from adjustment. Our chemists can reformulate or fine-tune a product to deliver the right balance of performance, material compatibility, and safety.
Process Optimization
It is clear that success in a lab doesn’t always mean success in production.The team analyzes process parameters such as temperature, dwell time, rinsing technique, agitation, and equipment setup, to refine each step for maximum consistency and throughput.
Pilot Validation and Scale-Up
When the approach proves successful in the lab, we assist with pilot production to confirm it performs under actual operating conditions before full-scale implementation.
Continued Partnership
Our relationship doesn’t end after your process is optimized. Chemtronics stays involved as materials evolve and compliance standards tighten. Our lab remains a resource for ongoing evaluation and innovation.

Why Engineers Rely on Chemtronics
Engineers come to Chemtronics because our testing reflects the realities of production. The testing is practical, the data is real, and the chemistries are proven to meet strict safety and compliance standards. Our team is aware of how chemistry and process come together, and we focus on solutions that make a measurable difference in reliability and throughput. Customers also appreciate that we stay involved afterward to support process improvements and future challenges.

How to Begin
- Tell us what’s not working or what you want to improve.
- Provide sample parts or boards for testing.
- Review the results and proposed process.
- Validate the process with a pilot trial.
- Move into production with confidence.
Collaborate with Chemtronics
When you’ve hit a wall with existing products or need a safer and more reliable process, the Chemtronics R&D lab is ready to help.
Reach out to our team to start testing your way to a better solution.